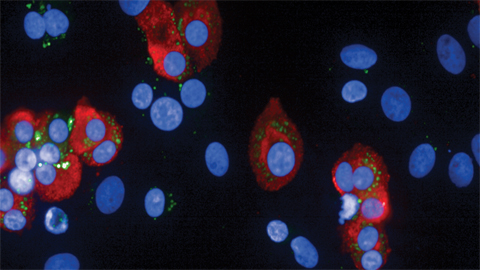

Contributors
Nathalie Gerassimov

Articles by Nathalie Gerassimov

Wellness
Mirror, mirror on the wall, which organs age fastest of them all?
Dec. 28, 2020
Using himself as a guinea pig, Michael Snyder has found that monitoring health baselines enables earlier disease diagnosis.

Journal News
Plasma membrane is no barrier to free fatty acid
Oct. 27, 2020
A recent paper describes how fatty acids spontaneously diffuse through protein-free lipid bilayers and the plasma membranes of cells.

Journal News
More than skin-deep
June 2, 2020
Researchers in Korea have found a novel bacterial lipase structure that may lead to new treatments for acne.

Diversity
The Meyerhoff Scholars Program: A model for increasing diversity in STEM
Feb. 12, 2020
“If we want to change the narrative and landscape — we need everyone at the table to understand the issues and do part of the work.” — Keith Harmon, MSP director

Award
Selenium led Zhao from icy hometown to German hospitality
Feb. 9, 2020
JBC/Tabor award winner Wenchao Zhao studies Keshan disease, a nutrient deficiency named for the county in northeastern China where he grew up.

Student Chapters
Premed from day 1 — researcher from day 3
Jan. 27, 2020
In his senior year, Koushik Muralidharan was elected ASBMB Student Chapter president at Monmouth University.

Journal News
From the journals: JBC
Jan. 3, 2020
Articles in the Journal of Biological Chemistry investigate immune receptor binding; barrel-shaped organelles called vaults; de novo dNTP synthesis; and a specific SNARE inhibitor.

Award
Campbell builds partnerships to study muscle biology
Nov. 1, 2019
This Herbert Tabor Research Award winner is described as "the world leader in the study of the molecular mechanisms of muscular dystrophy.”

Award
Allison focuses on thyroid hormone receptors and equity
Nov. 1, 2019
Allison’s support for diversity stems partially from her own experience in the 1980s when few women were high-ranking academic scientists.

News
Chasing the diagnostic potential of RNA editing
Sept. 1, 2019
A recent paper by Nick Davidson, co-editor-in-chief of the Journal of Lipid Research, deepens our understanding of tissue-specific regulation of programmed alteration of RNA in the intestine and the liver.

Journal News
From the journals: August 2019
Aug. 1, 2019
Curbing the neurotoxic effects of beta-amyloid plaques in Alzheimer’s. Using proteomics to find targets to treat leishmaniasis, a sometimes-deadly parasitic disease. Turning white fat cells brite to treat obesity. Read about this work and more.

Award
Tonks honored for seminal work on protein tyrosine phosphatases
April 1, 2019
For three decades, Nicholas Tonks has been making discoveries in the field of protein tyrosine phosphatases, or PTPs, enzymes that regulate the signal transduction cascades of many cellular processes.

Journal News
From the journals: April 2019
April 1, 2019
What structural features of a cortisol-producing enzyme could help in treating Cushing’s disease? Can melatonin be used to treat obesity? How does a gut pathogen evade antibiotic treatment? These and other questions are addressed in our roundup.

Wellness
Maternity in grad school — the best and worst of times
Jan. 1, 2019
In the sixth year of her Ph.D. studies, Nathalie Gerassimov became a mother. Even with plenty of self-discipline and a strong support system, it was exhausting — but also transforming.

Journal News
From the journals: January 2019
Jan. 1, 2019
What’s the link between chronic diabetes and cognitive decline? How does the body protect the liver during periods of fasting? Why do some pain drugs work in rodents but not in people?

Student Chapters
Her research evolved from chore to passion
Nov. 1, 2018
As a pre-med student, Grace Ferri, was urged by her advisers to do research — and fell in love with crystallography.
Journal News
From the journals: October 2018
Oct. 1, 2018
A gene that can both increase and decrease diabetes risk. A protein that makes tumor cells more aggressive. Citrus compounds that reverse obesity. Read about these topics and more in our roundup of recent papers from the Journal of Biological Che…

Award
Tsin, a mentor to many, advances diversity
April 1, 2018
Andrew Tsin, an expert in retinal neurobiology, “worked tirelessly, one-on-one, with research trainees in his lab, sustained over a period of more than 30 years.”

Award
Clarke stands out with seminal discoveries in protein methylation and inspired teaching
April 1, 2018
Steven Clarke of the University of California, Los Angeles, illuminated how protein modifications by methyl groups regulate fundamental biological processes.

Journal News
JBC: A focus on iron
Dec. 1, 2017
The 10th installment of a thematic review series in the Journal of Biological Chemistry
explores the king of metals in biology.

Journal News
JLR: The art and science of breathing
June 1, 2017
Researchers found that a gene variant in patients with pulmonary alveolar proteinosis affects the activation of a protein called ABCG1.

Journal News
JBC: Researchers decipher how barbiturates work
April 1, 2017
Researchers solved how barbiturates function to induce anesthesia.